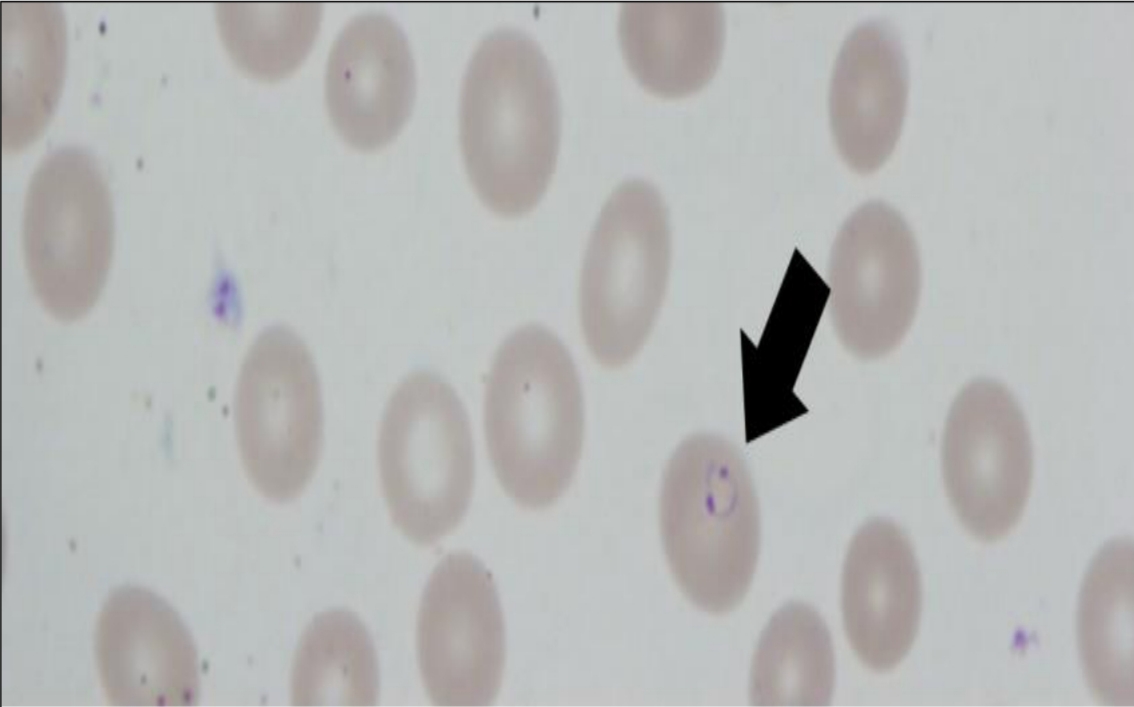
term image
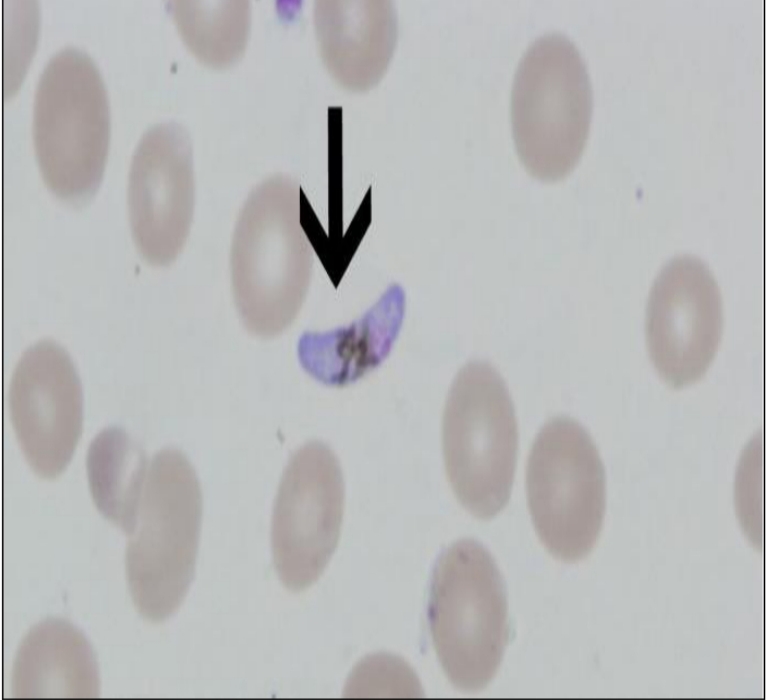
term image
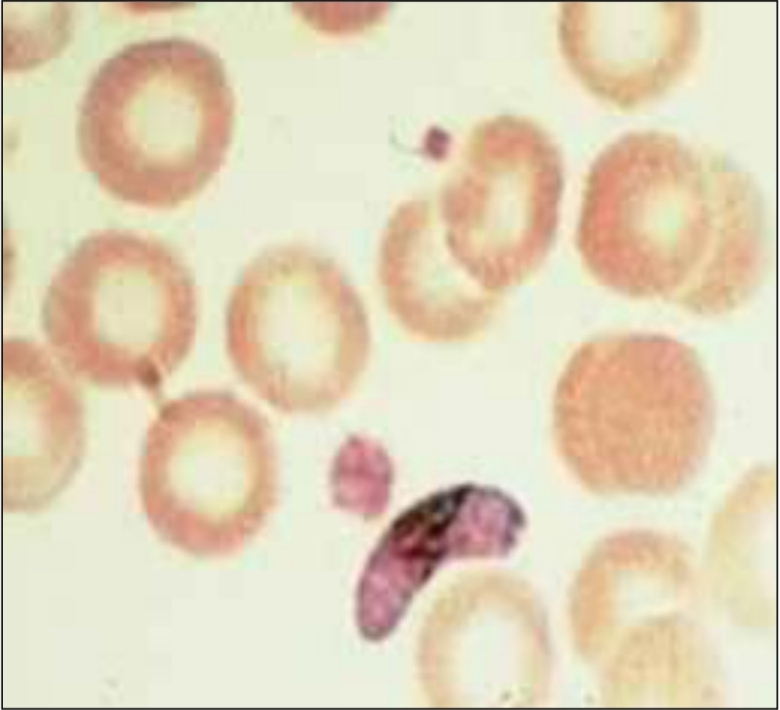
term image

Parasitology Spots (data show)
1/68
There's no tags or description
Looks like no tags are added yet.
Name | Mastery | Learn | Test | Matching | Spaced |
|---|
No study sessions yet.
69 Terms

Trophozoite of Entamoeba histolytica

Trophozoite of Entamoeba histolytica, containing RBCs

Mature quadrinucleated cyst of Entamoeba histolytica

Mature quadrinucleated cyst of Entamoeba histolytica

Trophozoite of Giardia lamblia

Mature quadrinucleated cyst of Giardia lamblia

Balantidium coli trophozoite

Balantidium coli trophozoite

Balantidium coli cyst

Trichomonas vaginalis trophozoite

Female sand fly

Leishmania promastigotes

Leishmania amastigotes located intracellularly within mammalian host macrophages

Tsetse fly

Female Anopheles mosquito
Plasmodium ring shaped trophozoite

Plasmodium ring shaped trophozoite

Plasmodium schizont
Plasmodium falciparum gametocyte
Plasmodium falciparum gametocyte

Toxoplasma gondii sporulated oocyst

Toxoplasma gondii sporulated oocyst

Toxoplasma gondii sporulated oocyst

Trypanosoma trypanomastigotes

Trypanosoma trypomastigotes

Lymnaea snail (intermediate host of Fasciola)

Fasciola cercaria

Fasciola metacercaria (infective stage)

Bladder biopsy showing Schistosoma haematobium eggs

Schistosoma cercaria (infective stage)

Bulinus snail (intermediate host of Schistosoma haematobium)

Biomphalaria snail (intermediate host of Schistosoma mansoni)

Pirenella conica snail (first intermediate host of Heterophyes heterophyes)

Schistosoma haematobium egg (diagnostic stage)

Schistosoma haematobium egg (diagnostic stage)

Schistosoma mansoni egg (diagnostic stage)

Schistosoma mansoni egg (diagnostic stage)

Heterephyes eggs (diagnostic stage)

Gravid progglotids of Taenia saginata (diagnostic stage)

Gravid progglotids of Taenia solium (diagnostic stage)

Hymenolepis nana egg

Hydatid cyst of Echinococcus granulosus demonstrating two daughter cysts containing multiple scoleces

Taenia saginata scolex

Taenia solium scolex

Taenia sp. wheel-shaped eggs

Hymenolepis nana adult worm

Echinococcus granulosus adult worm

Anterior end of Ascaris lumbricoides showing 3 lips around the mouth

Ascaris lumbricoides fertilized corticated egg (diagnostic stage)

Ascaris lumbricoides unfertilized egg (diagnostic stage)

Enterobious vermicularis adult male (diagnostic stage)

Enterobious vermicularis adult male (diagnostic stage)

Enterobious vermicularis adult female (diagnostic stage)

Ancylostoma duodenale adult (diagnostic)

Anterior end of Ancylostoma duodenale showing buccal capsule containing teeth (diagnostic)

Ancylostoma duodenale egg (diagnostic)

Ascaris lumbricoides adult worm (diagnostic)

Ascaris lumbricoides fertilized decorticated egg (diagnostic stage)

Enterobious vermicularis anterior end showing esophageal bulb

Posterior end of Ancylostoma duodenale male showing copulatory bursa (diagnostic)

Enterobious vermicularis egg (diagnostic AND infective stage)

Strongyloides stercoralis 1st stage rhabditiform larva (diagnostic stage)

Strongyloides stercoralis 1st stage rhabditiform larva (diagnostic stage)

Posterior end of filariform larve of Strongyloides stercoralis with notched tail (infective stage)

Encysted Trichinella spiralis larva in muscle tissue (diagnostic and infective stage)

Elephantiasis (caused by Wuchereria bancrofti filaria)

Wuchereria bancrofti microfilaria (diagnostic stage)

Trichocephalus trichuris worm

Trichocephalus trichuris egg